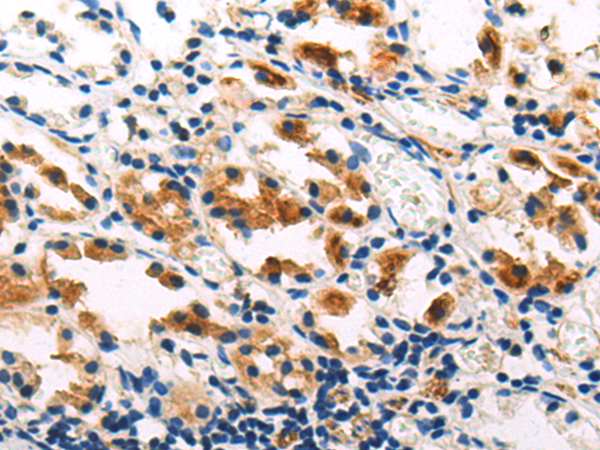
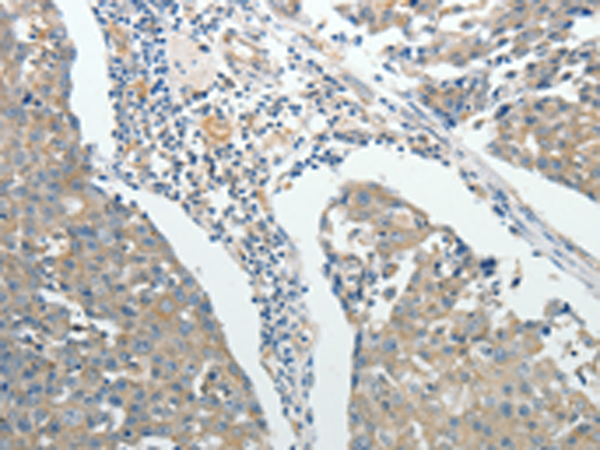
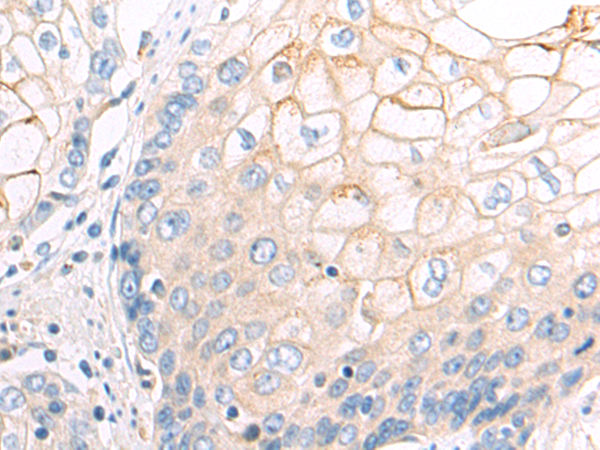
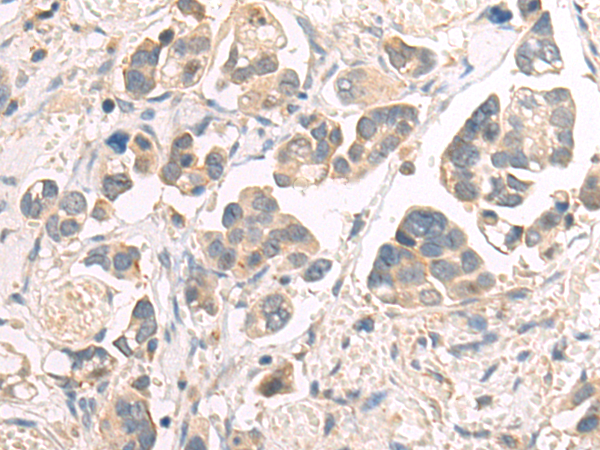

-
分类: 科研抗体货号: P07594别名: SIR2L6应用: WB反应种属: Human, Mouse
-
分类: 科研抗体货号: P07573别名: HHM, PLP, BDE2, PTHR, PTHRP应用: IHC反应种属: Human, Mouse, Rat
-
分类: 科研抗体货号: P07583别名: P0; LP0; L10E; RPP0; PRLP0应用: WB,IHC反应种属: Human, Mouse, Rat
-
分类: 科研抗体货号: P07593别名: SIR2L3应用: WB,IHC反应种属: Human, Mouse
-
分类: 科研抗体货号: P07605别名: SNAPA应用: WB,IHC反应种属: Human, Mouse, Rat
-
分类: 科研抗体货号: P07582别名: ROCK-II应用: WB,IHC反应种属: Human, Mouse, Rat
-
分类: 科研抗体货号: P07592别名: SIP1; SIP-1; ZFHX1B; HSPC082; SMADIP1应用: IHC反应种属: Human, Mouse
-
分类: 科研抗体货号: P07604别名: HA1756应用: WB,IHC反应种属: Human, Mouse, Rat
-
分类: 科研抗体货号: P07581别名: ROCK-I; P160ROCK应用: IHC反应种属: Human, Mouse, Rat
-
分类: 科研抗体货号: P07591别名: CFC; NS1; JMML; SHP2; BPTP3; PTP2C; METCDS; PTP-1D; SH-PTP2; SH-PTP3应用: WB,IHC反应种属: Human, Mouse, Rat

鄂公网安备42018502007531号
鄂公网安备42018502007531号

